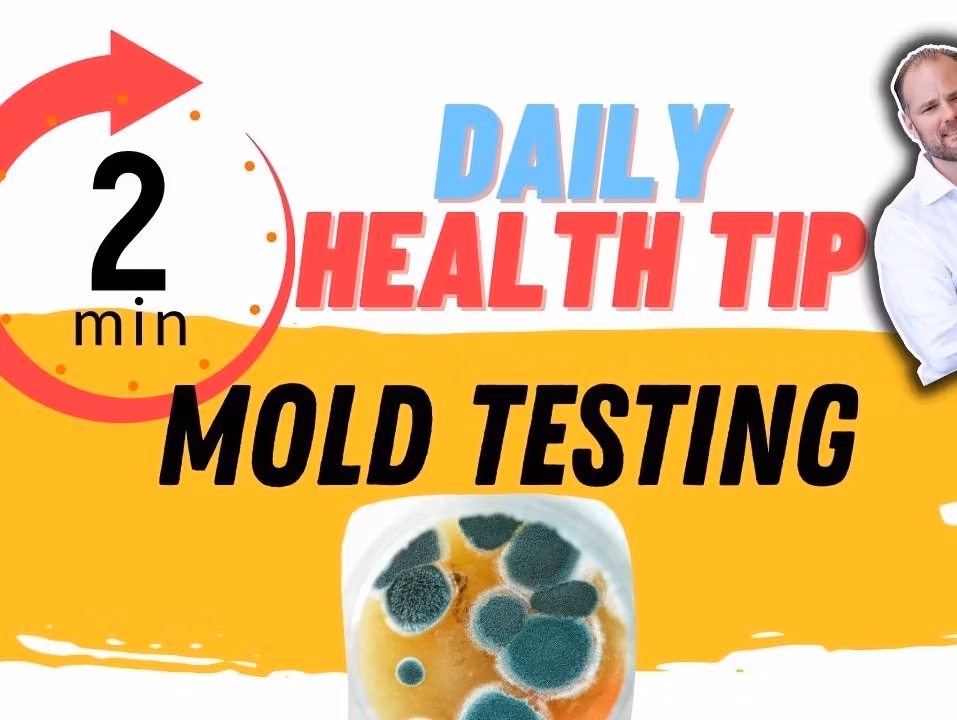

Low White Blood Cell Count? Hidden Toxins May Be the Real Culprit

Discover how mold toxins, heavy metals, and pollution trigger low white blood cells and high CRP—plus a simple three-step detox plan.
Fluoroquinolone Poisoning + Mold: Urine Tests Show 90% Toxin Drop in 12 Weeks

Struggling with blurred vision, bladder trouble or tremors after fluoroquinolones? This blog shows a real mold toxicity case, with Great Plains urine test charts and a gentle protocol that cleared spores without crash. Learn how to recover from being floxed today.
Your Doctor Missed This About Your Fibromyalgia Pain

Struggling with fibromyalgia? Learn how mold, gut health, and autoimmune issues may be behind your pain.
Fibromyalgia Recovery: 3 Hidden Reasons You’re Still in Pain

Three critical reasons you might still be suffering with fibromyalgia symptoms even after diagnosis and treatment.
Struggling with Mystery Symptoms? Test for Hidden Mold, Metals, and Pollutants in Your Body!

If you’re feeling sick without a clear cause, hidden culprits like mold, heavy metals, and environmental toxins may be at play. These factors can silently impact your immune system and overall health. Discover how to identify and address these hidden threats for better well-being.
Mold of 5700 to ZERO in 9 months | See 4 follow up tests!

Mold exposure and chronic mold infection can cause huge problems for the body including depression, fatigue, digestive issues, and infection
Putting the Brakes on Neuropathy and Mold

Learn how fish oil supports myelin repair, reduces inflammation, and may help manage neurological conditions and chronic pain. Ensure proper dosage and quality for best results.
Mold Exposure and Its Impact on Gut Health

Learn how hidden mold exposure can impact your health and why proper testing for mold toxicity is essential for accurate diagnosis and recovery.
Mold Side Effects: Unveiling the Hidden Culprit Behind Chronic Conditions

Explore the serious side effects of mold exposure through real patient experiences and understand how it can impact your health and recovery journey.
Mold testing explained in one-minute!
Living with a chronic health condition? Mold could be the hidden cause. Affordable at-home testing is available—schedule a call with Dr. Hugh today!